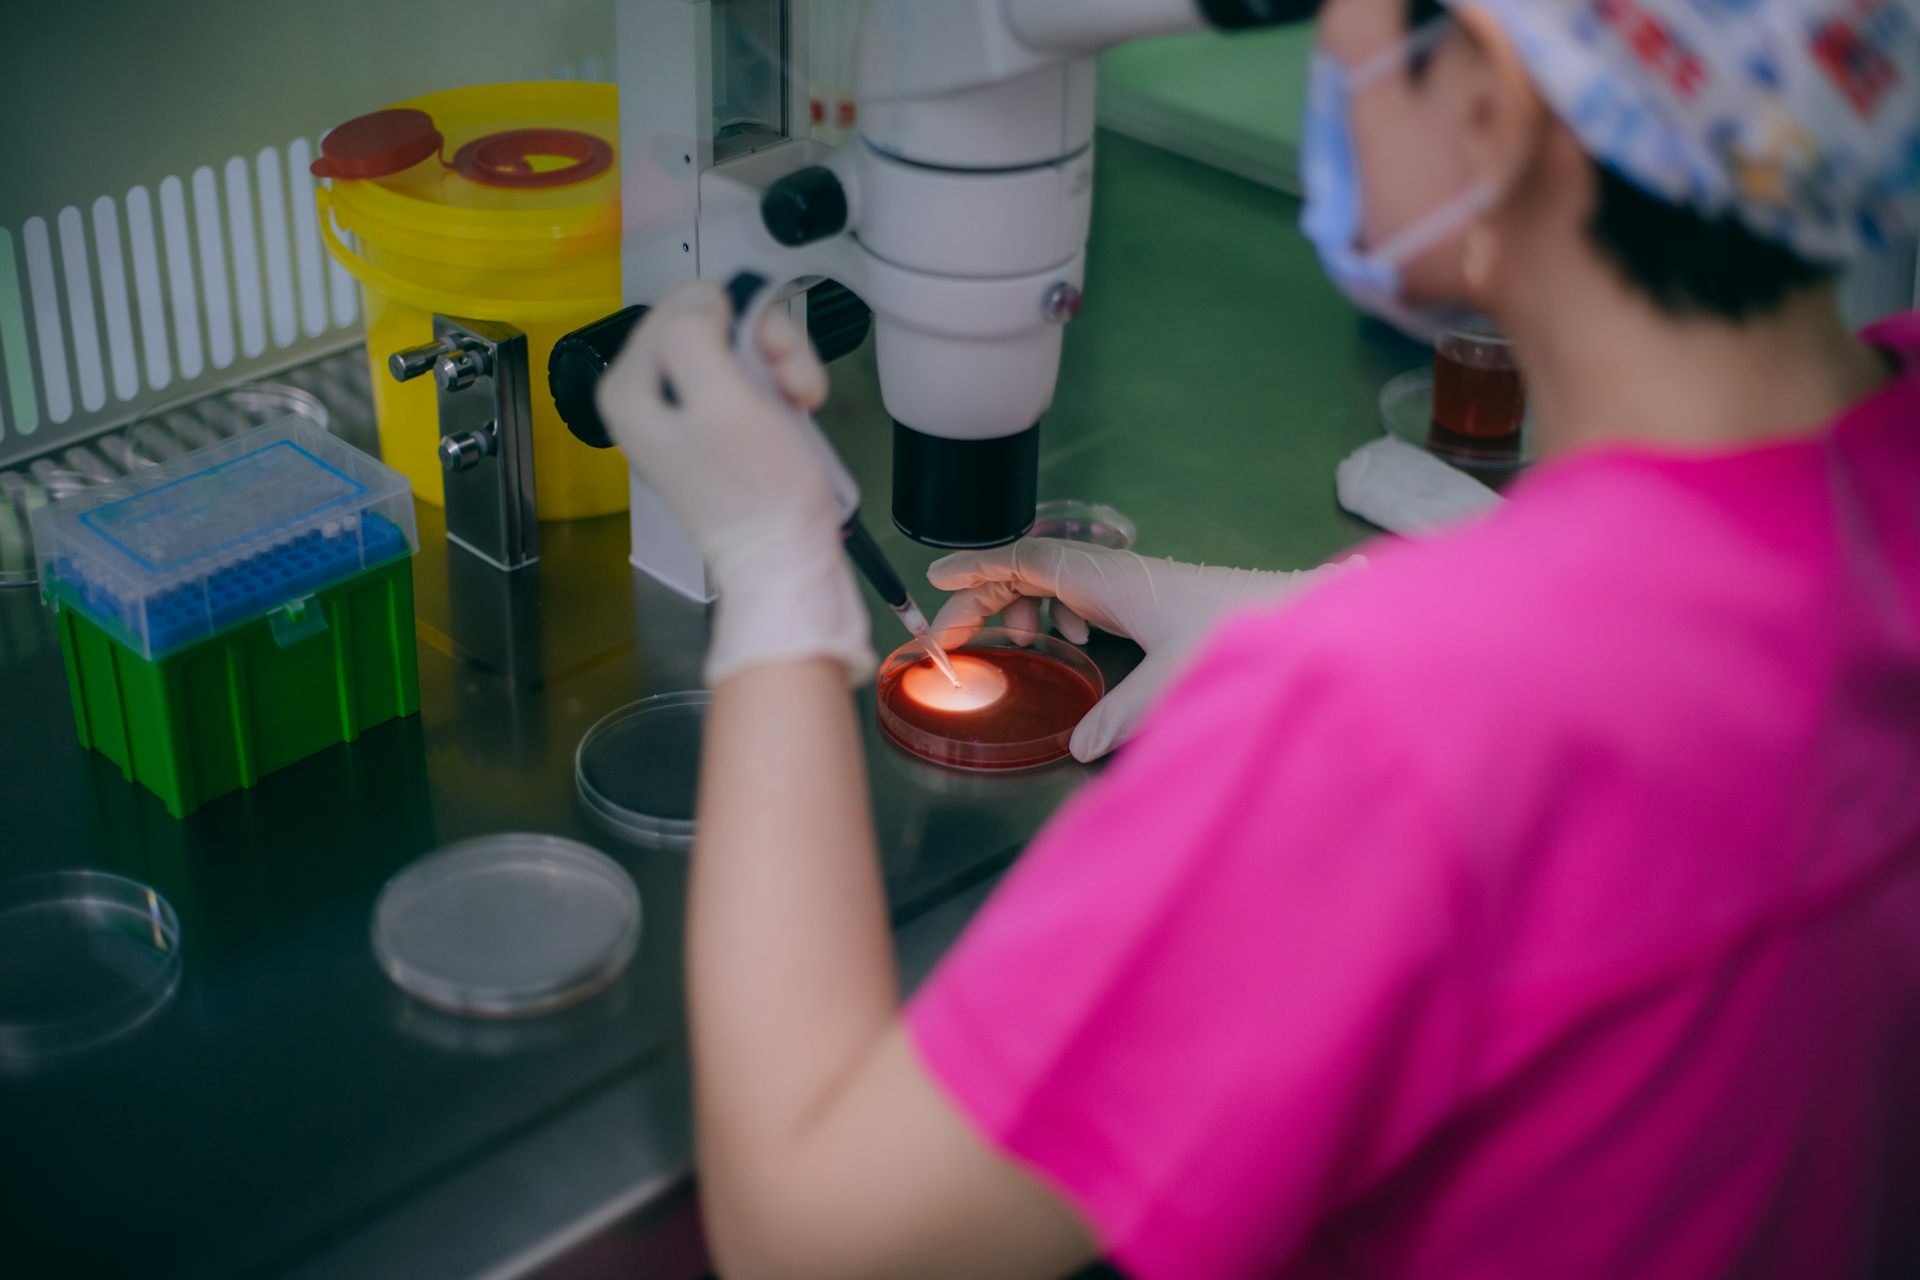

Source: The Conversation – (in Spanish) – By Mauro Turrini, Postdoctoral research fellow, Centro de Ciencias Humanas y Sociales (CCHS – CSIC)
Existen miles de enfermedades genéticas, por lo que es lógico que a muchas parejas les preocupe la posibilidad de transmitir una a su descendencia, incluso aunque ellos estén sanos. Hoy existe una tecnología que puede evitar este riesgo. Suena a ciencia ficción, pero es cada vez más común leer este tipo de mensaje en los sitios web de las clínicas privadas de fertilidad españolas.
Y es que las posibilidades tecnológicas para intervenir en la reproducción asistida son muy amplias y están avanzando rápidamente. Esto permite actuar en etapas cada vez más tempranas del proceso reproductivo.
Entre las tecnologías de reproducción asistida se encuentra la “prueba genética preimplantacional” (PGT, por sus siglas en inglés). Esta técnica consiste en analizar el material genético de un embrión antes de colocarlo en el útero. Promete así evaluar la calidad de los embriones y poder descartar los “no saludables” o “anormales”.
Cada vez más personas se enfrentan a esta decisión. La mera oferta de estas tecnologías abre espacio para reflexionar sobre nuevas formas de responsabilidad y obligación. En España, el uso del PGT se está incrementando de manera constante. En los últimos diez años su utilización ha aumentado drásticamente, pasando de 3161 en 2012 a más de 20 500 en 2022.
En realidad, el PGT abarca tres tecnologías diferentes con distintos objetivos y destinatarios:
-
El PGT-M y el PGT-SR son herramientas diagnósticas utilizadas para evitar transmitir enfermedades genéticas específicas.
-
El PGT-A se presenta como una estrategia para mejorar las tasas de éxito de la fecundación in vitro (FIV) y prevenir mutaciones cromosómicas espontáneas. Por ejemplo, el síndrome de Down.
A diferencia de las otras variantes, el PGT-A puede ofrecerse a cualquier persona que se someta a una fecundación in vitro, pero su eficacia es muy debatida. Algunos estudios indican que podría incluso reducir las tasas de éxito. Esto ocurriría al descartar embriones que podrían haber resultado en embarazos viables.
En California esta controversia acabó en una demanda colectiva contra clínicas por haber descartado embriones que habrían podido convertirse en bebés sanos.
No sorprende que, mientras que el PGT-M y el PGT-SR se practican en la mayoría de países europeos, el uso del PGT-A esté mucho más restringido. Sin embargo, en España el sector de la fertilización in vitro es ampliamente comercial y privatizado y el PGT-A es bastante común. Las clínicas privadas ofrecen este test como un servicio extra con un coste adicional, llamado un “add-on” (complemento).
Entre la divulgación y la publicidad
Estudios recientes han investigado la comunicación online de las clínicas privadas españolas. Estos han revelado un discurso a medio camino entre la divulgación médica y el mensaje publicitario.
En muchos casos no se diferencia entre el PGT-A y las otras variantes (el PGT-M y el PGT-SR). Tampoco se mencionan las incertidumbres que rodean al primero. Esto lleva a que habitualmente las tecnologías se presenten como una sola –complementaria al tratamiento de fertilización in vitro– que puede aumentar las posibilidades de éxito, identificar mutaciones hereditarias en genes específicos y detectar mutaciones espontáneas.
Otro hallazgo relevante de estos estudios es que la comercialización del PGT está dirigida directamente a las mujeres. Frases como “cumple tu sueño de ser madre”, así como hashtags como #SerMadre, #Mujer o #Maternidad se repiten a lo largo de las páginas web y redes sociales de las clínicas.
Estos discursos reproducen la idea estereotipada de que son las mujeres de quienes se espera que tomen las decisiones reproductivas.
Un ‘seguro’ frente al reloj biológico
Las clínicas insisten en que la edad materna es un motivo importante para optar por el uso del PGT. Metáforas reiteradas como la del “reloj biológico” evocan de manera insistente que el deterioro de la fertilidad femenina, asociado a la edad, constituye una de las principales causas de la aparición de embriones “defectuosos” o “en riesgo” de desarrollar mutaciones espontáneas.
Las clínicas animan a las mujeres a no dejar que “el tiempo se les eche encima” y a recurrir a las tecnologías reproductivas si no han iniciado su proceso reproductivo “a tiempo”.
En este contexto, el PGT-A se presenta como una especie de seguro de fertilidad frente al paso del tiempo. Es decir, como un acto racional, una inversión inteligente que busca reducir no solo los costes económicos, sino sobre todo el sufrimiento emocional asociado a los abortos de repetición.
A la vez, las clínicas presentan la decisión de realizar el test como un “acto de amor” hacia el futuro hijo o hija, reforzando la idea de que una buena madre previene el dolor antes de que ocurra. El embrión, denominado “el paciente más pequeño de la clínica” y tratado como una “persona en formación”, legitima la intervención precoz y sitúa a las mujeres como responsables del bienestar de sus potenciales futuros hijos.
La tecnología no es neutra
Lógicas biomédicas, económicas y afectivas se entrelazan, responsabilizando a las mujeres de optimizar sus embriones en nombre del cuidado y de gestionar racionalmente su planificación familiar. Así, el PGT se convierte en objeto de vigilancia y evaluación que contribuye a moldear qué decisiones pueden (y deben) tomar las futuras madres.
En definitiva, la proliferación de innovaciones –especialmente en un ámbito tan privatizado y comercial como la reproducción asistida en España– puede ofrecer grandes oportunidades, pero estas tecnologías no son herramientas neutrales. La forma en que se presentan y se comercializan influye en cómo entendemos la maternidad, la responsabilidad genética y el acceso a la salud.
Por eso, resulta fundamental una comunicación clara, honesta y crítica, que priorice el bienestar de quienes atraviesan estos tratamientos por encima de los intereses del mercado.
![]()
Mauro Turrini recibe fondos proyecto de investigación «IfGene: Proyectando el futuro de la predicción genética» (PID2020‐115899GB‐I00), financiado por el Ministerio de Ciencia e Innovación (MICIU) a través de la Agencia Estatal de Investigación (AEI) (MICIU/AEI/10.13039/501100011033), con el apoyo del Fondo Europeo de Desarrollo Regional (FEDER).
Astrid Boe Hüttel ha recibido fondos del proyecto de investigación «IfGene: Proyectando el futuro de la predicción genética» (PID2020‐115899GB‐I00), financiado por el Ministerio de Ciencia e Innovación (MICIU) a través de la Agencia Estatal de Investigación (AEI) (MICIU/AEI/10.13039/501100011033), con el apoyo del Fondo Europeo de Desarrollo Regional (FEDER).
– ref. Pruebas genéticas en reproducción asistida: entre las promesas de salud y el ‘marketing’ dudoso – https://theconversation.com/pruebas-geneticas-en-reproduccion-asistida-entre-las-promesas-de-salud-y-el-marketing-dudoso-255136
